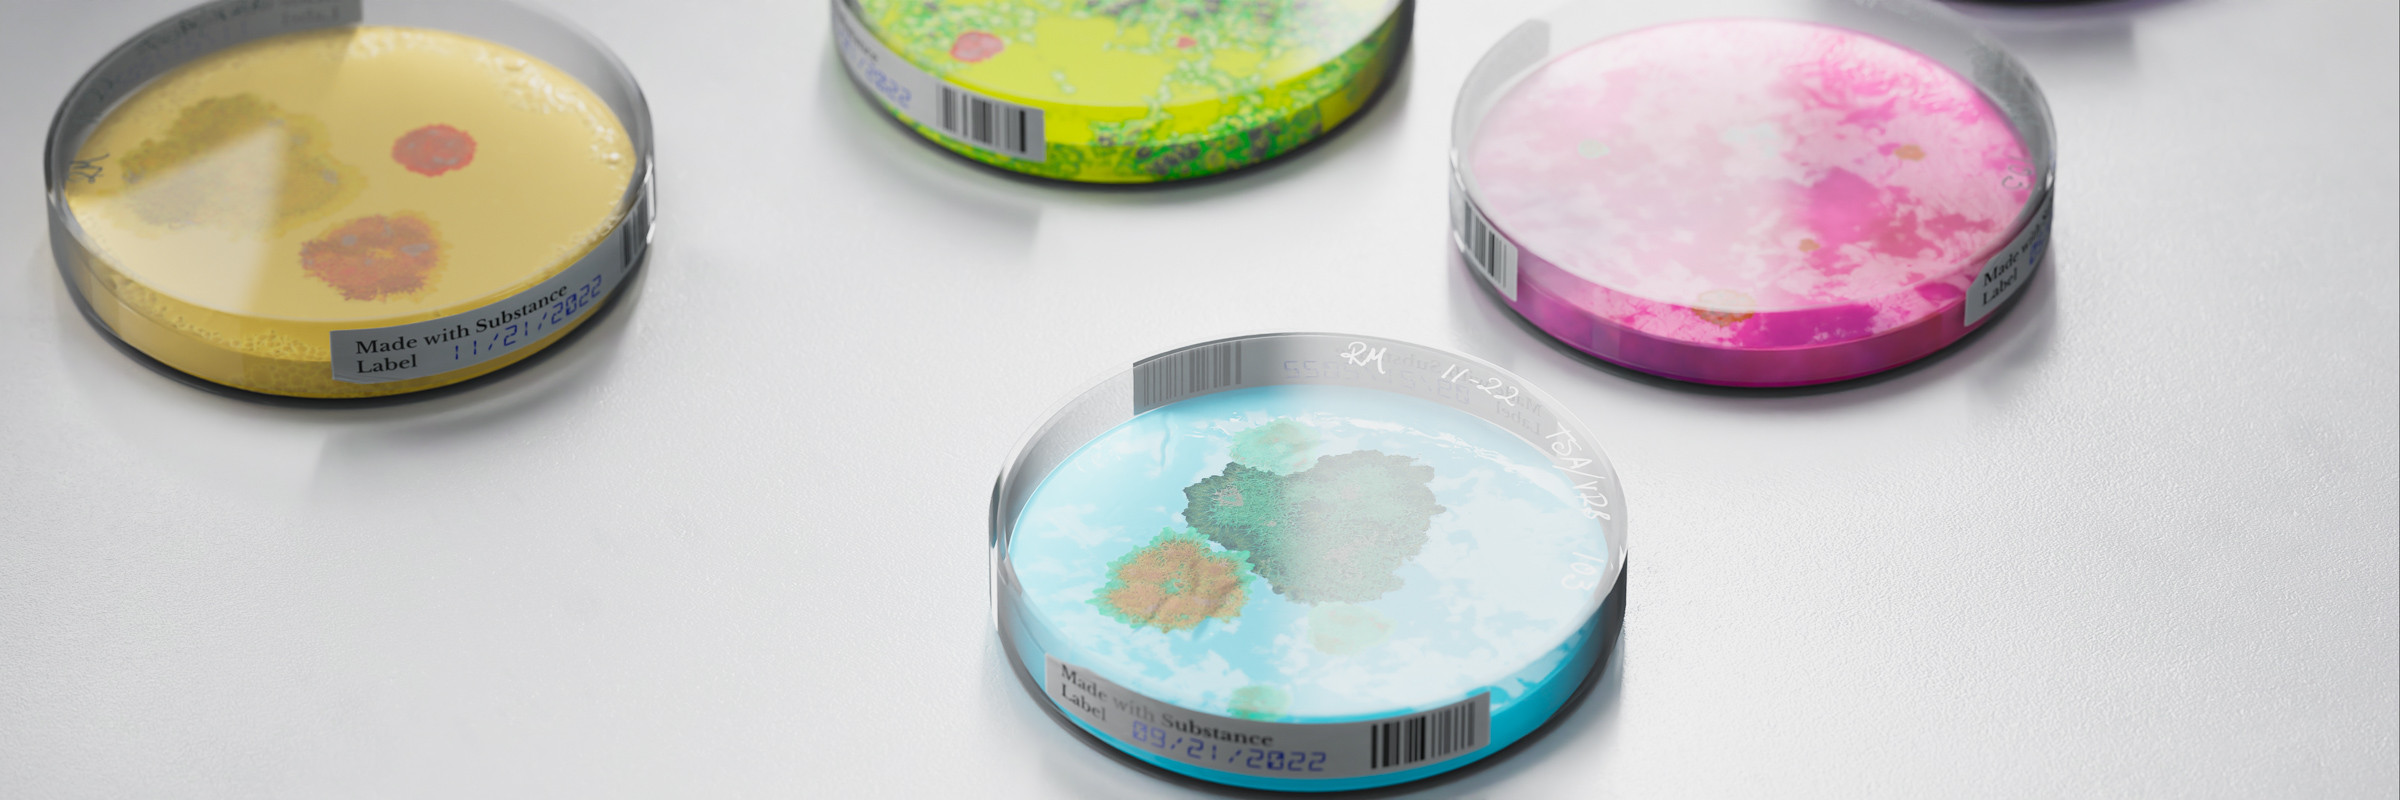

Substance 3D - Laboratory
A showcase of the Laboratory collection of assets from Substance 3D Asset library.
Key assets such as microscope textured in Substance painter, models and materials from the asset library.
Good fun testing lighting scenarios using the environment light stages, via an HDRI blueprint to quickly iterate lighting.
Rendered in Unreal Engine 5.1
You can see the collection on Adobe
https://substance3d.adobe.com/assets/collections/f8739f1cf38c60d3f404a4290a052ca410404cca
0